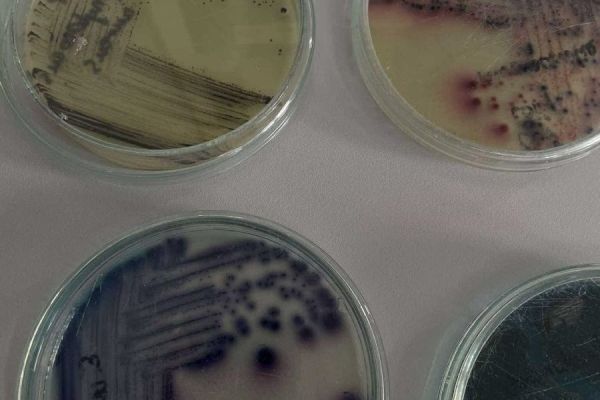
messenger-creation-eea7f29b-09ed-41a8-bf9f-5820cb707675AD7DE09D-AEC1-F2BE-CF8B-806790FA62F0.jpg

W dniu 13 grudnia 2024 r. uczniowie klasy 2i uczestniczyli w zajęciach laboratoryjnych z chemii i biologii, zorganizowanych w ramach projektu Via Carpatia
przez Katedrę Chemii, Biologii i Biotechnologii Politechniki Białostockiej.
W trakcie spotkania uczniowie przeprowadzali doświadczenia laboratoryjne (właściwości białek, denaturacja, właściwości i wykrywanie aminokwasów w białkach), oglądali pod mikroskopem mikroorganizmy pochodzące z osadu czynnego.
Serdecznie dziękujemy Katedrze Chemii, biologii i Biotechnologii za możliwość udziału w tak ciekawych zajęciach.
Monika Czuba